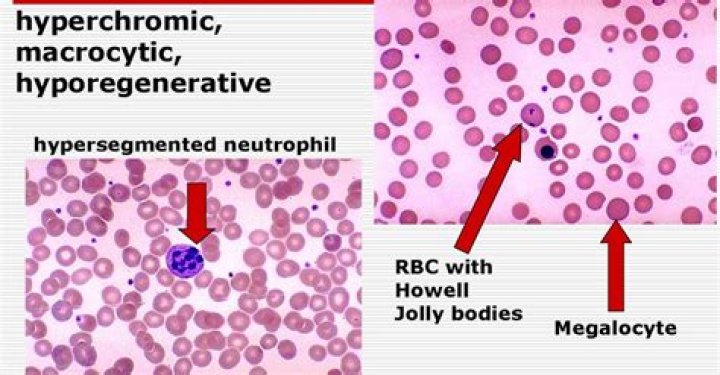

How is Macrocytic treated
Treating macrocytic anemia This can be done with supplements or foods like spinach and red meat. You may be able to take supplements that include folate and other B vitamins. You may also need vitamin B-12 injections if you don’t absorb oral vitamin B-12 properly.
How is macrocytic anemia diagnosed?
Diagnosis is usually based on a complete blood count and peripheral smear, which usually shows a macrocytic anemia with anisocytosis and poikilocytosis, large oval red blood cells (macro-ovalocytes), Howell-Jolly bodies (residual fragments of the nucleus), hypersegmented neutrophils, and reticulocytopenia.
Who is at risk for macrocytic anemia?
Common risk factors of megaloblastic anemia include nutritional factors, alcoholism, elderly, pregnant, vegans, and malabsorptive syndromes.
What happens if macrocytosis is left untreated?
If severe macrocytosis is left untreated for periods longer than six months, however, neurological complications due to low oxygen levels in the body can develop. Individuals with macrocytosis due to pernicious anemia have an increased risk of developing stomach polyps (benign growths) and stomach cancer.What are the two most common causes of macrocytic anemia?
- medications, including HIV drugs, cancer drugs, and others that suppress the immune system.
- liver disease.
- hypothyroidism.
- rare metabolic disorders.
Does Macrocytic anemia cause fatigue?
Macrocytosis is a condition in which the red blood cells (RBCs) are larger than normal but not functioning as they should. It can cause fatigue, and sometimes there are other symptoms related to underlying causes of macrocytosis.
What is the treatment for high red blood cell count?
Care and Treatment If a medical condition is causing a high red blood cell count, your doctor may recommend a procedure or medication to lower it. In a procedure called a phlebotomy, a health professional inserts a needle into your vein and drains blood through a tube into a bag or container.
What medications can cause Macrocytic anemia?
Common drugs that cause macrocytosis are hydroxyurea, methotrexate, zidovudine, azathioprine, antiretroviral agents, valproic acid, and phenytoin (Table 1).How serious is macrocytosis without anemia?
Macrocytosis without anemia is unlikely to result in specific signs or symptoms, and in many cases, may have minimal clinical significance. Patients should be screened for symptoms of anemia, including fatigue, generalized weakness, dyspnea, palpitations, lightheadedness, and syncopal or near-syncopal events.
Does high MCV mean liver disease?Macrocytosis is a useful diagnostic indicator of alcoholism. MCV values greater than 100 fl in patients with liver disease almost invariably indicate alcohol-related disease. In the short-term, changes in MCV are of little use in monitoring alcohol intake.
Article first time published onDoes high B12 mean leukemia?
An abnormally high vitamin B-12 status can be an early sign of liver disease, diabetes, or certain types of leukemia. A doctor may use the results of a vitamin B-12 test to help form their diagnosis.
How long does it take for MCV to return to normal?
Stopping heavy drinking allows the bone marrow to recover, and the MCV usually returns to normal within two months.
What do enlarged red blood cells indicate?
Macrocytosis is a condition in which your red blood cells are larger than they should be. While it isn’t a condition of its own, macrocytosis is a sign that you have an underlying health condition and may lead to a severe form of anemia called macrocytic normochromic anemia.
What are the symptoms of B12 and folate deficiency?
- extreme tiredness.
- a lack of energy.
- pins and needles (paraesthesia)
- a sore and red tongue.
- mouth ulcers.
- muscle weakness.
- disturbed vision.
- psychological problems, which may include depression and confusion.
Does Macrocytic anemia cause low hematocrit?
Macrocytic anemia refers to macrocytosis (mean corpuscular volume (MCV) greater than 100 fL) in the setting of anemia (hemoglobin less than 12 g/dL or hematocrit (Hct) less than 36% in nonpregnant females, hemoglobin less than 11 g/dL in pregnant females, or hemoglobin less than 13 g/dL or Hct less than 41% in males).
Is MCV 105 high?
An average MCV score is between 80 and 95. If the MCV goes up to an extreme of 125, it may indicate vitamin B12, folate deficiencies, or cold agglutinin disease. A higher MCV value indicates that the red blood cells are larger than the average size.
Is MCV 102 high?
An MCV of 102 is slightly large, and can be seen in many conditions. Vitamin B-12 and folic acid deficiencies are the ones we usually first look for, but some medications can cause it, as can alcohol, as you mention. Some genetic conditions, like hereditary spherocytosis, can do it.
Is MCV 104 high?
An MCV test measures the size and volume of red blood cells. A normal MCV range is roughly 80–100 fl . If someone’s MCV level is below 80 fl, they will likely develop or have microcytic anemia. Alternatively, if their MCV levels are greater than 100 fl, they could experience macrocytic anemia.
How can I lower my red blood cells naturally?
- Exercise to improve your heart and lung function.
- Eat less red meat and iron-rich foods.
- Avoid iron supplements.
- Keep yourself well hydrated.
- Avoid diuretics, including coffee and caffeinated drinks, which can dehydrate you.
- Stop smoking, especially if you have COPD or pulmonary fibrosis.
Is it bad if your red blood cells are high?
An RBC count that is higher than normal can be a sign of many health problems, including: Dehydration. Lung diseases. Heart diseases.
Can high red blood cells cause anxiety?
Background: Depression and anxiety are two common mood disorders that are both linked to systemic inflammation. Increased white blood cell (WBC) count and red cell distribution width (RDW) are associated with negative clinical outcomes in a wide variety of pathological conditions.
Which nutrients are needed to prevent Microcytic anemia?
Prevention. In some cases, such as with an inherited disorder, there is no proven way to prevent microcytic anemia completely. Eating a balanced diet high in iron, vitamin B12, vitamin C, and folic acid can be helpful for almost anyone with anemia.
Why is my MCH and MCV high?
Causes of high MCH levels High MCH scores are commonly a sign of macrocytic anemia. This condition occurs when the blood cells are too big, which can be a result of not having enough vitamin B12 or folic acid in the body. High MCH scores may also be the result of the following: liver diseases.
How does anemia affect the brain?
Recent findings: Severe anaemia, or low haematocrit, has been associated with cognitive dysfunction, impaired cerebral vascular regulation, neurological injury, and increased mortality, which suggests that the brain is vulnerable to anaemia-induced injury.
Can macrocytosis be normal?
The prevalence of macrocytosis in general population is reported to range between 1.7 and 3.6% [1, 2]. Physiological macrocytosis is seen in pregnancy, newborns and infants. Macrocytosis without anemia may sometimes be a normal variant found in members of the same family, suggesting a genetic predisposition.
What is a major cause of Microcytosis?
The most common causes of microcytosis are iron deficiency anemia and thalassemia trait. Other diagnoses to consider include anemia of chronic disease, lead toxicity, and sideroblastic anemia.
Is macrocytosis and Macrocytic anemia the same?
Macrocytosis means that the red blood cells are larger than normal. Macrocytic anaemia occurs when there is also a fall in haemoglobin levels in the blood. Anaemia is usually defined as a haemoglobin level of at least two standard deviations below the mean for that age and sex.
Can acetaminophen cause Macrocytic anemia?
Acetaminophen is broken down into a toxic chemical, called N-acetyl-para-benzoquinoneimine (NAPQI) which can damage red blood cells, causing anemia, and altering the oxygen carrying capabilities of the iron and hemoglobin within the red blood cell.
What are signs that your liver is struggling?
- Fatigue and tiredness. …
- Nausea (feeling sick). …
- Pale stools. …
- Yellow skin or eyes (jaundice). …
- Spider naevi (small spider-shaped arteries that appear in clusters on the skin). …
- Bruising easily. …
- Reddened palms (palmar erythema). …
- Dark urine.
Is autoimmune hemolytic anemia serious?
Autoimmune hemolytic anemia (AIHA) is a group of rare but serious blood disorders. They occur when the body destroys red blood cells more rapidly than it produces them. A condition is considered idiopathic when its cause is unknown. Autoimmune diseases attack the body itself.
How can I lower my MCV and MCH levels?
Treatment for low MCH caused by iron deficiency can include adding iron-rich foods to your diet (there are even vegetarian options) and taking iron supplements. In rare cases, such as when symptoms are severe or blood loss has occurred, you may need a blood transfusion.



